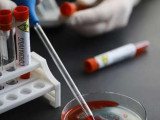
Елімізде тағы 335 адам коронавирус жұқтырды

Вирус
Үкімет • 18 Маусым, 2020
Асқар Мамин Елбасының сауығып кетуін тіледі
Премьер-Министр Асқар Мамин Тұңғыш Президент – Елбасы Нұрсұлтан Назарбаевқа сырқатынан тезірек айығып шығуын тіледі. Бұл туралы Премьер-Министрдің баспасөз қызметі хабарлады.
Президент • 18 Маусым, 2020
Президент күнделікті коронавирусқа тест тапсырып жатыр
Мемлекет басшысы Қасым-Жомарт Тоқаев күнделікті коронавирусқа тест тапсырып жатыр. Бұл туралы баспасөз хатшысы Берік Уәли Facebook парақшасында жазды, - деп хабарлады Egemen.kz
Елбасы • 18 Маусым, 2020
Қасым-Жомарт Тоқаев Елбасының тезірек сауығып кетуін тіледі
Мемлекет басшысы Қасым-Жомарт Тоқаев Елбасы Нұрсұлтан Назарбаевтың тезірек сауығып кетуін тіледі, - деп хабарлайды Egemen.kz.
Аймақтар • 18 Маусым, 2020
Алматыда індеттің белең алуына байланысты карантин режимі қайта күшейтіледі
Бұл туралы бүгін қала басшысы Бақытжан Сағынтаев өзінің әлеуметтік парақшасында жариялады, - деп хабарлайды Egemen.kz.
Қазақстан • 18 Маусым, 2020
Қазақстанда 20-21 маусымда шектеу шаралары күшейтіледі
Премьер-Министр Асқар Маминнің төрағалығымен Қазақстан аумағында коронавирус инфекциясының таралуына жол бермеу жөніндегі ведомствоаралық комиссияның (ВАК) селекторлық отырысы өтті. Президент Қасым-Жомарт Тоқаевтың тапсырмасына сәйкес Қазақстандағы эпидемиологиялық жағдайды тұрақтандыру бойынша қосымша шаралар қаралды, - деп хабарлайды Egemen.kz.
Аймақтар • 18 Маусым, 2020
Қостанай облысында карантин режімі қайта күшейді
Бүгін коронавирус індетіне қарсы өңірлік жедел штаб отырысында облыс әкімі Архимед Мұхамбетов соңғы күндері аймақтағы эпидемиологиялық аһуалдың асқынып бара жатқанын атап өтті, - деп хабарлайды Egemen.kz.
Аймақтар • 18 Маусым, 2020
Атырауда қауіпті індеттен екі әйел көз жұмды
Коронавирустың құрсауынан шыға алмай, қайтыс болғандар – 73 және 40 жастағы әйелдер, - деп хабарлайды Egemen.kz.
Коронавирус • 18 Маусым, 2020
Атыраудағы Ұлттық сараптама орталығы филиалының 14 қызметкері індетке шалдықты
Кеше филиалдың бір қызметкерінен коронавирус инфекциясы анықталған екен, - деп хабарлайды Egemen.kz.
Аймақтар • 18 Маусым, 2020
Қарағанды облысының бас дәрігері: Үйге жүгірмеңіз, дәрігерге жүгініңіз
Коронавирус инфекциясының алғашқы белгілері байқалған кезде, мәселен дененің ыстығы көтеріліп, жөтел пайда болып немесе дәм айыру сезімі бәсеңдей бастаған жағдайда үйге тығылудың еш қажеті жоқ. Себебі, бірден дәрігердің көмегіне жүгінбей, өз бетінше емделу – зардабы ауыр болатын асқынуларға әкеліп соғуы әбден мүмкін. Бұл туралы Қарағанды облыстық денсаулық сақтау басқармасының басшысы Ержан Нұрлыбаев онлайн-брифингте айтып берді, – деп хабарлайды Egemen.kz.
Қазақстан • 18 Маусым, 2020
Қаржы министрі оқшаулануға кетті
Қаржы министрі Ерұлан Жамаубаев өзін өзі оқшаулау режиміне көшті, - деп хабарлайды Egemen.kz
Видео • 18 Маусым, 2020
COVID-19 вирусы анықталғанда не істеген жөн?
COVID-19 вирусы алғаш анықталғанда қарапайым, бірақ аса маңызды ережелерді ескерген абзал. Дер кезінде қажетті шараларды қолдану - індеттен жылдам арылып, оның таралмауы үшін жасаған әрекетіңіз болмақ.
Әлем • 18 Маусым, 2020
Қазіргі уақытта Перуде вирус жұқтырғандардың саны 240 908 құрайды, бұл Италияға қарағанда әлдеқайда көп. Бұл туралы BBC News агенттігіне сілтеме жасай отырып Egemen.kz хабарлайды.
Әлем • 18 Маусым, 2020
Францияда медицина қызметкерлері шеруге шықты
Карантин кезінде миллиондаған француз қол шапалақтап, коронавируспен күресіп жатқан медицина қызметкерлеріне құрмет көрсеткен еді. Енді олар шеруге шығып, құрал-жабдықтардың жетіспеуіне наразылық білдірді, - деп жазады Egemen.kz
Әлем • 18 Маусым, 2020
Әлемде вирус жұқтырғандар саны 8,3 млн-нан асты
18 маусым күні Johns Hopkins University (JHU) ұсынған мәлімет бойынша әлемде вирус жұқтырғандар саны – 8 349 519, өлім саны – 448 958, айыққандар саны – 4 073 924 адам болды, - деп жазады Egemen.kz.
Коронавирус • 18 Маусым, 2020
Қазақстанда коронавирустан қайтыс болғандар саны 100-ге жетті
18 маусымдағы сағат 10:00-дегі мәлімет бойынша Қазақстанда коронавирус инфекциясынан 3 адам қайтыс болды, - деп хабарлайды Egemen.kz.
Әлем • 18 Маусым, 2020
Германияда бір күнде 580 адам коронавирус жұқтырды
Германияда жаңа типті коронавирус инфекциясын бір күнде 580 адам жұқтырып үлгерді. Оның 26-сы қайтыс болды. Бұл туралы Федералды денсаулық сақтау министрлігінің қарамағындағы Роберт Кох институты хабарлайды, деп жазады Egemen.kz
Аймақтар • 18 Маусым, 2020
Павлодар облысында 13 адамнан коронавирус анықталды
COVID-19 1957, 1960, 1988, 1992, 1991, 1990, 1995 жылы туған ер адамдардан және 1964, 1968, 1973, 1974, 1975, 1988 жылы туған әйел адамдардан анықталды, - деп хабарлайды Egemen.kz.
Коронавирус • 18 Маусым, 2020
Коронавирус белгілері жоқ тағы 656 тасымалдаушы тіркелді
Қазақстанда 17 маусымда COVID-19 ауруының клиникалық белгілері байқалмайтын 656 тасымалдаушы тіркелді, - деп хабарлайды Egemen.kz.
Коронавирус • 18 Маусым, 2020
Елімізде тағы 335 адам коронавирус жұқтырды
Қазақстанда өткен тәулікте тағы 335 адам індет жұқтырды, - деп хабарлайды Egemen.kz.
Коронавирус • 17 Маусым, 2020
Қазақстанда коронавирустан 9 адам көз жұмды
Бұл туралы ДСМ баспасөз қызметі хабарлады, - деп жазады Egemen.kz
Коронавирус • 17 Маусым, 2020
Бұл жаңалықты бүгін түс ауа ДДСҰ жариялады. Медицина тілінде "дексаметазон" деп аталатын дәрінің бағасы 10 АҚШ долларынан аз тұрады. Әлем халқын көп күттірген препарат 1960 жылдан бері қолданыста ие екен, - деп хабарлайды Egemen.kz ДДСҰ-ның сайтына сілтема жасап.
Президент • 17 Маусым, 2020
Ертең Үкімет тестілеу ауқымын кеңейту туралы шараларды жариялайды
Мемлекет басшысы Қасым-Жомарт Тоқаев ертең Үкімет эпидемиологиялық жағдайды тұрақтандыруға байланысты шараларды жариялайтынын айтты, - деп хабарлайды Egemen.kz.
Әлем • 17 Маусым, 2020
Африкада қанша инфекция тіркелді?
Өткен аптада Дүниежүзілік денсаулық сақтау ұйымы (ДДҰ) Африкада коронавирустың таралуы жеделдеп жатқандығын ескертті, деп жазады Egemen.kz
Коронавирус • 17 Маусым, 2020
Күннен күнге айтып жатқан суық хабар соғыстан келіп жатқан қаралы қағаз сияқты. Түрі жаман. Көзге көрінбейтін соғыс, сырттан келген жау дерсің.
Аймақтар • 17 Маусым, 2020
Инфекция жұқтырған жағдайда өзімізді қалай ұстауымыз керек
Коронавирус инфекциясының ауру белгілері жоқ формасы оң нәтиже көрсеткен жағдайда – бұл шағымдардың және клиникалық белгілердің болмауы, өкпені инструменталды (аспапты) көзбен шолу кезінде патологиялық өзгерістер болмайды, - деп жазады Egemen.kz
Әлем • 17 Маусым, 2020
Тұманды Альбионды "қиын кезеңдер күтіп тұр"...
Тұманды Альбионның премьер-министрі Борис Джонсон коронавируспен байланысты дағдарыстан шығу кезеңінде Ұлыбритания үшін «қиын кезеңдер» туатыны туралы ескертті. Бұл туралы BBC News агенттігіне сілтеме жасай отырып Egemen.kz хабарлайды.
Қоғам • 17 Маусым, 2020
Елордада базарлар мен сауда үйлеріне рейд жүргізілді
Нұр-Сұлтан қаласы Сарыарқа ауданындағы базарлар мен сауда үйлеріне санитарлық нормалардың сақталуына рейд жүргізілді, - деп хабарлайды қала әкімдігінің баспасөз қызметі.
Әлем • 17 Маусым, 2020
Оңтүстік Кореяда вируспен ауырғандар саны 12198-ге артты
Оңтүстік Кореяда күніне COVID-19-дың 43 жаңа жағдай тіркелуде. Індет жұқтырғандардың жалпы саны 12198-ге дейін ұлғайса, ал 10774-і жазылып шықты. Ал оның 279-ы қайтыс болды. Бұл туралы Денсаулық сақтау министрлігі жанындағы Ауруларды бақылау және алдын алу орталығы (KCDC) хабарлайды, деп жазады Egemen.kz
Білім • 17 Маусым, 2020
Коронавирус індеті экономикаға, күнделікті өмірге және білім саласына көптеген өзгерістер әкелді. Қазір технологиялар мектепте қосымша білім беру немесе ойын-сауық ретінде ғана емес, сонымен қатар оқушыларды толықтай оқыту үшін де таптырмас құрал болып табылады. Пандемиядан кейін мектептегі білім беру қаншалықты өзгеретінін қарастырып көрейік.
Аймақтар • 17 Маусым, 2020
Павлодар облысы әкімдігінің қызметкерлері вирустан аман-есен
Павлодар облысының әкімі Әбілқайыр Сқақов және оның орынбасарлары кесте бойынша бейнеконференция режімінде жұмыстарын жалғастыруда, деп хабарлайды Egemen.kz